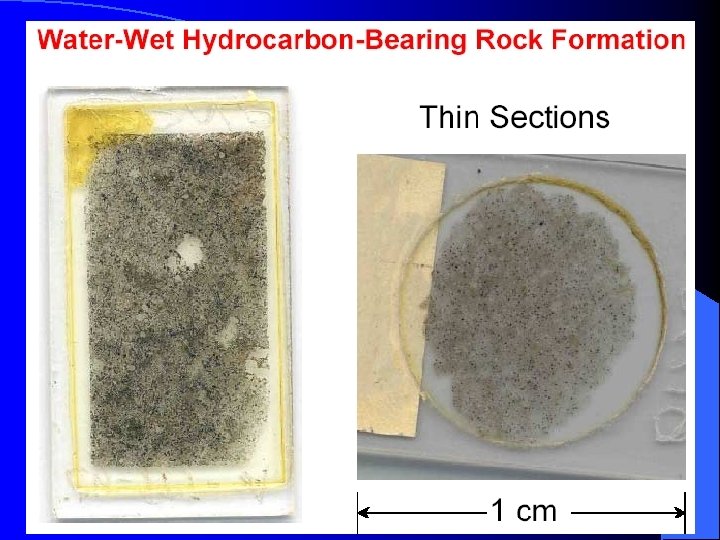

Some basic Log interpretation Mastery Items What is

Some basic Log interpretation Mastery Items: What is the Archie Equation and why is it important? Basic reservoir characteristics? Basic source rock characteristics? Lithology identification and determination

Archie Equation for Sw and Sxo Water saturation (Sw) of reservoir’s uninvaded zone is calculated by the Archie (1942) formula. Where: Sw = water saturation of the uninvaded zone (Archie method) Rw = resistivity of formation water at formation temperature Rt = true resistivity of formation (i. e. RIld or RLLd corrected for invasion) Ø = porosity a = tortuosity factor m = cementation exponent n = saturation exponent which varies from 1. 8 to 2. 5 but is normally equal to 2. 0

Archie Equation for Sw and Sxo Where: Sw = water saturation of the uninvaded zone (Archie method) Rmf = resistivity of the mud filtrate at formation temperature Rxo = shallow resistivity from Laterolog-8*, Micropherically Focused Log*, or Microlaterolog* f = porosity a = tortuosity factor m = cementation exponent n = saturation exponent which varies from 1. 8 to 2. 5 but is normally equal to 2. 0 Water saturation of the flushed zone (Sxo) can be used as an indicator of hydrocarbon moveability

Ratio Method The Ratio Method identifies hydrocarbons from the difference between water saturations in the flushed zone (Sxo) and the uninvaded zone (Sw). when water saturation of the uninvaded zone (Sw) is divided by water saturation of the flushed zone (Sxo), the following results: Where: Sw = water saturation uninvaded zone Sxo = water saturation flushed zone Rxo = formation’s shallow resistivity from Laterolog-8*, Microspherically Focused Log*, or Microlaterolog* Rt = formation’s true resistivity (RIld or RLLd corrected for invasion) Rmf = resistivity of the mud filtrate at formation temperature Rw = resistivity of the formation water at formation temperature

Basic reservoir characteristics l Porosity, φ (Total, effective, primary, secondary and intercrystalline) l Permeability (K) (Absolute, relative) l Saturation (S) (Sw, Sxo, Sh, So, Sg, Shr, Shm) and their interrelationships.

POROUS MEDIUM STANDARD REALITY

Various pore geometries with different effective path length

Water-Wet Hydrocarbon-Bearing Formation

Basic source rock characteristics l Determination of organic mattr content l Determination of organic carbon content

Basic source rock characteristics l Determination of organic mattr content l Determination of organic carbon content

SOURCE ROCK EVALUATION Organic matter content can he determined directly from laboratory analyses of the source rock samples (shale, limestone or marl), but indirect methods based on wireline data offer the advantages of economic, ready availability of data and continuity of sampling of vertically heterogeneous shale section. A hydrocarbon source rock evaluation system is preliminary revealed by showing the effect of the implicated organic material on the responses of some specific types of logs as gamma-ray, resistivity, density and sonic logs. The total organic matter content of the shale can be calculated either from the gamma-ray or the density logs.

Discrimination of Source Rocks from Non-Source Rocks There is a simple classification rule for separating source rocks from non-source rocks on the basis of quantitative wireline log parameters. Two equations have been used to discriminate roughly the source rocks from the non-source rocks, on the basis of log combinations (Sonic-Resistivity) and (Density-Resistivity).

Bulk Volume of Water The product of a formation’s water saturation (Sw) and its porosity (f) is the bulk volume of water (BVW). BVW = Sw x Ø Where: BVW = bulk volume water Sw = water saturation of uninvaded zone (Archie equation) Ø = porosity

LITHOLOGY IDENTIFICATION AND DETERMINATION In oil field logging applications, the prime importance is directed to define the types and amounts of fluids encountered in the formations. These determinations require the calculation of the formation porosity, consequently the estimation of the shale volume. Thus, the shale content is an important quantitative function of log analysis. VOLUME OF SHALE Shale volume is needed for correcting the porosity and water saturation results for the biased effects of shale. It is considered as an indicator for reservoir quality, in which the lower shale content usually reveals a better reservoir quality. In addition to the shale volume, it is important to determine the types of shale for choosing the appropriate shale model, which can be utilized for selecting the suitable water saturation model.

DETERMINATION OF MATRIX COMPONENTS The simultaneous equations are considered an analytical way used normally for accomplishing this target. Such equations have important applications in the mathematical field. Their uses are also extended to the geological fields, in which they are utilized in the formation evaluation to determine the lithologic contents and the accompanied porosities in fractions . It can be more easy through the use of the computer system, due to the complexity of their solution by manual treatment. There are four equations reflecting the normal rock constituents (porosity + shale + silica + carbonate) for every type of the porosity tools (sonic, density and neutron).

DETERMINATION OF POROSITIES Porosity is the volume of the non-solid portion of the rock, that is filled with fluids divided by the total volume of the rock. Primary porosity is the porosity developed by the original sedimentation process, by which the rock was created. It is often referred to in terms of percentage Rock porosities are usually measured from well logs and corrected using the porosity tools (Density, Neutron and Sonic). These porosity tools are largely responsive to porosity and, also, affected by other geologic factors, e. g. formation matrix lithology, type of fluid present in the pores and the type of porosity. This has allowed the use of these logs in combination for the determination of the total porosity ( T), as well as the secondary porosity ( sec) and effective porosity ( E).
- Slides: 17